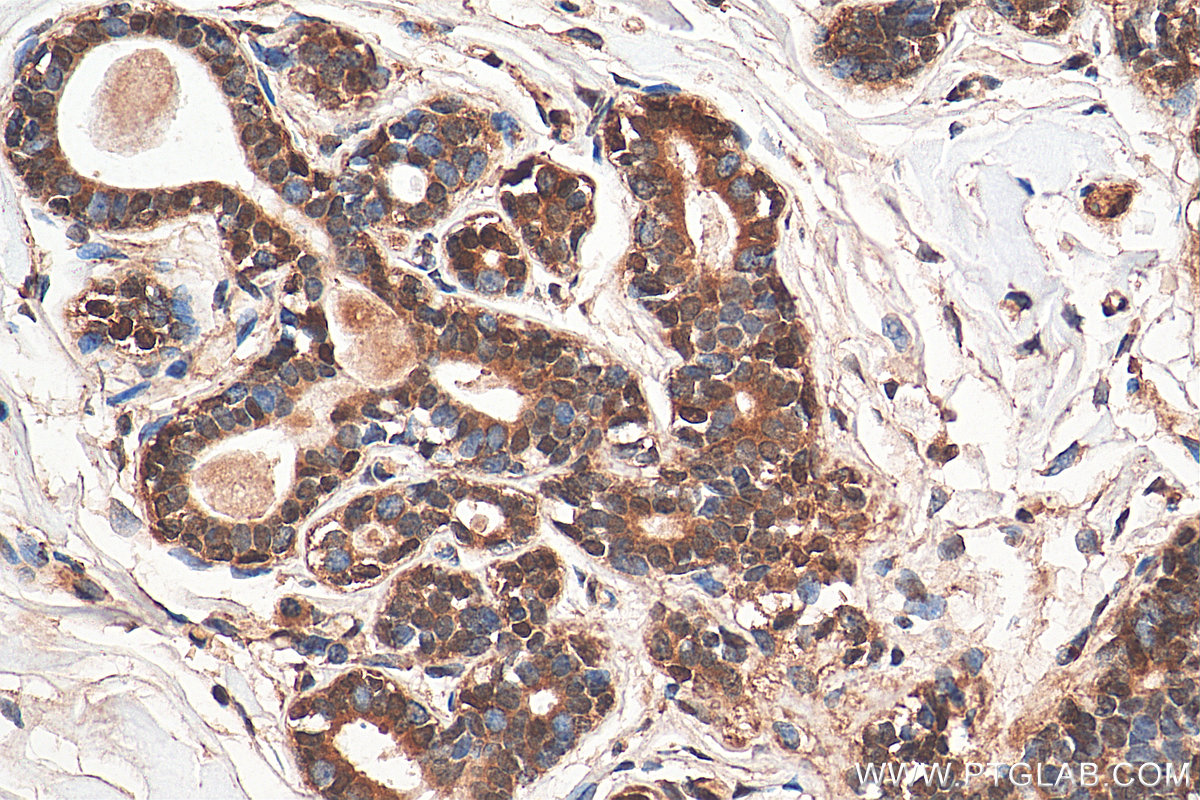

验证数据展示
经过测试的应用
| Positive WB detected in | A549 cells, A431 cells, HeLa cells, Jurkat cells, K-562 cells, MCF-7 cells, PC-12 cells, NIH/3T3 cells |
| Positive IP detected in | HeLa cells |
| Positive IHC detected in | human stomach cancer tissue, human colon cancer tissue, human cervical cancer tissue, mouse colon tissue, human breast cancer tissue Note: suggested antigen retrieval with TE buffer pH 9.0; (*) Alternatively, antigen retrieval may be performed with citrate buffer pH 6.0 |
| Positive IF/ICC detected in | HeLa cells, IFN alpha treated HeLa cells |
| Positive FC (Intra) detected in | Ramos cells |
推荐稀释比
| 应用 | 推荐稀释比 |
|---|---|
| Western Blot (WB) | WB : 1:2000-1:16000 |
| Immunoprecipitation (IP) | IP : 0.5-4.0 ug for 1.0-3.0 mg of total protein lysate |
| Immunohistochemistry (IHC) | IHC : 1:50-1:500 |
| Immunofluorescence (IF)/ICC | IF/ICC : 1:50-1:500 |
| Flow Cytometry (FC) (INTRA) | FC (INTRA) : 0.40 ug per 10^6 cells in a 100 µl suspension |
| It is recommended that this reagent should be titrated in each testing system to obtain optimal results. | |
| Sample-dependent, Check data in validation data gallery. | |
产品信息
10253-2-AP targets STAT3 in WB, IHC, IF/ICC, FC (Intra), IP, CoIP, ChIP, RIP, ELISA applications and shows reactivity with human, mouse, rat samples.
| 经测试应用 | WB, IHC, IF/ICC, FC (Intra), IP, ELISA Application Description |
| 文献引用应用 | WB, IHC, IF, FC (Intra), IP, CoIP, ChIP, RIP |
| 经测试反应性 | human, mouse, rat |
| 文献引用反应性 | human, mouse, rat, pig, zebrafish, bovine, marmoset |
| 免疫原 |
CatNo: Ag0360 Product name: Recombinant human STAT3 protein Source: e coli.-derived, PGEX-4T Tag: GST Domain: 2-219 aa of BC000627 Sequence: AQWNQLQQLDTRYLEQLHQLYSDSFPMELRQFLAPWIESQDWAYAASKESHATLVFHNLLGEIDQQYSRFLQESNVLYQHNLRRIKQFLQSRYLEKPMEIARIVARCLWEESRLLQTAATAAQQGGQANHPTAAVVTEKQQMLEQHLQDVRKRVQDLEQKMKVVENLQDDFDFNYKTLKSQGDMQDLNGNNQSVTRQKMQQLEQMLTALDQMRRSIVS 种属同源性预测 |
| 宿主/亚型 | Rabbit / IgG |
| 抗体类别 | Polyclonal |
| 产品类型 | Antibody |
| 全称 | signal transducer and activator of transcription 3 (acute-phase response factor) |
| 别名 | Acute-phase response factor, APRF, HIES, STAT 3 |
| 计算分子量 | 770 aa, 88 kDa |
| 观测分子量 | 88 kDa |
| GenBank蛋白编号 | BC000627 |
| 基因名称 | STAT3 |
| Gene ID (NCBI) | 6774 |
| RRID | AB_2302876 |
| 偶联类型 | Unconjugated |
| 形式 | Liquid |
| 纯化方式 | Antigen affinity purification |
| UNIPROT ID | P40763 |
| 储存缓冲液 | PBS with 0.02% sodium azide and 50% glycerol, pH 7.3. |
| 储存条件 | Store at -20°C. Stable for one year after shipment. Aliquoting is unnecessary for -20oC storage. |
背景介绍
Signal transducer and activator of transcription 3 (acute-phase response factor) (STAT3, synonyms: APRF, FLJ20882, MGC16063) is a member of the STAT protein family. In response to cytokines and growth factors, STAT family members are phosphorylated by the receptor associated kinases, and then form homo- or heterodimers that translocate to the cell nucleus where they act as transcription activators. STAT3 is activated through phosphorylation in response to various cytokines and growth factors including IFNs, EGF, IL5, IL6, HGF, LIF and BMP2. STAT3 mediates the expression of a variety of genes in response to cell stimuli, and thus plays a key role in many cellular processes such as cell growth and apoptosis. The small GTPase Rac1 has been shown to bind and regulate the activity of STAT3. This antibody is a rabbit polyclonal antibody raised against residues near the N terminus of human STAT3. STAT3 exists three isoforms and the molecular weight of each isoform respectively is 83 kDa, 87 kDa and 88 kDa.
实验方案
| Product Specific Protocols | |
|---|---|
| IF protocol for STAT3 antibody 10253-2-AP | Download protocol |
| IHC protocol for STAT3 antibody 10253-2-AP | Download protocol |
| IP protocol for STAT3 antibody 10253-2-AP | Download protocol |
| WB protocol for STAT3 antibody 10253-2-AP | Download protocol |
| Standard Protocols | |
|---|---|
| Click here to view our Standard Protocols |
发表文章
| Species | Application | Title |
|---|---|---|
Cancer Cell Targeting the immune privilege of tumor-initiating cells to enhance cancer immunotherapy | ||
Brain Behav Immun l-Cysteine suppresses hypoxia-ischemia injury in neonatal mice by reducing glial activation, promoting autophagic flux and mediating synaptic modification via H2S formation. | ||
Adv Sci (Weinh) DNA Origami-Based CD44-Targeted Therapy Silences Stat3 Enhances Cartilage Regeneration and Alleviates Osteoarthritis Progression |